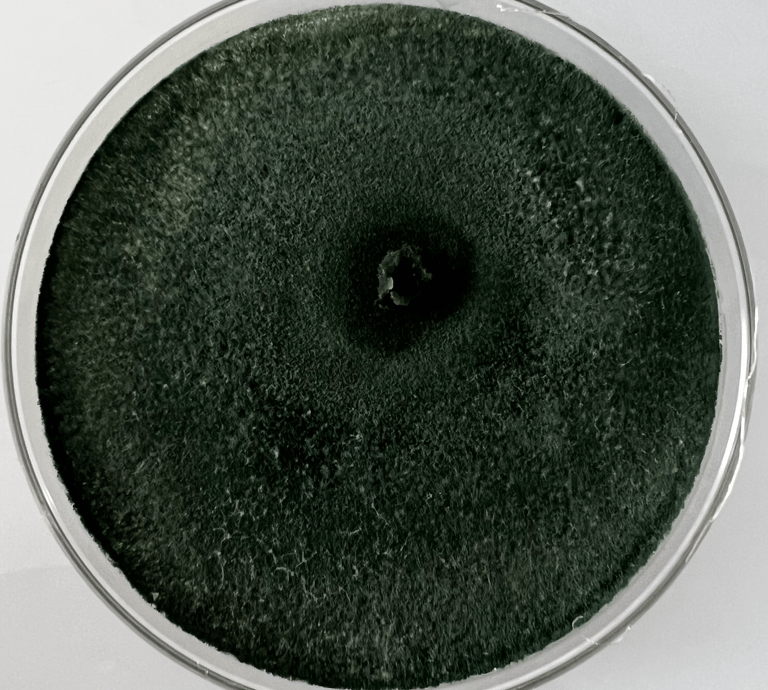
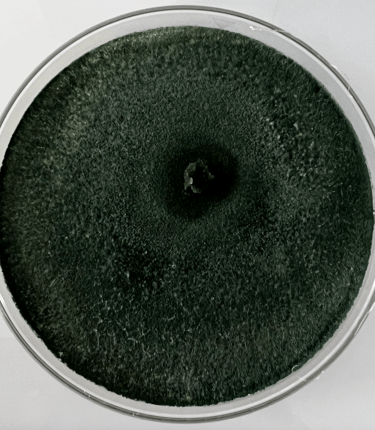

Trichoderma Harzianum
Producto orgánico a base del hongo antagonista Trichoderma Harzianum para un cultivo más saludable y sostenible en tu negocio agrícola.
Bienvenidos a Avilab
su aliado.
Ofrecemos Trichoderma harzianum, un producto biológico y orgánico que controla enfermedades causadas por hongos en los cultivos
Promueve el crecimiento saludable de las plantas y mejora la productividad agrícola.
Ofrecemos de forma garantizada de 12 a 14 millones de UFC (unidades formadoras de colonias)
Nuestro Trichoderma no es modificado genéticamente y trabaja perfectamente bajo condiciones extremas (temperatura y humedad)

Excelente producto, resultados sorprendentes.
"
Servicios Biológicos
Trichoderma harzianum un producto orgánico para enriquecer la salud de la Rizosfera de tu suelo.
Control Biológico
Previene el ataque de los patógenos


Efecto vigorizánte
Promueve el crecimiento de las plantas
Contamos con el equipo especializado para identificación de enfermedades de sus cultivos
Consultoría Especializada




ALGUNAS ENFERMEDADES QUE CONTROLA
Estas son un ejemplo de algunas de las enfermedades Fitopatogenas que controla Trichoderma












Fusarium
Pythium
Phymatotrichopsis
Alternaria
Macrophomina
Rhizoctonia
El producto de Avilab ha mejorado significativamente la salud de mis cultivos. ¡Altamente recomendado!
Alejandro B.


★★★★★
TRICHODERMA
Producto Biologico
CONTACTO
avilabtrichoderma@gmail.com
Oficina: +52 6621 989645
Whatsapp: +526629489509
© 2024. All rights reserved.
